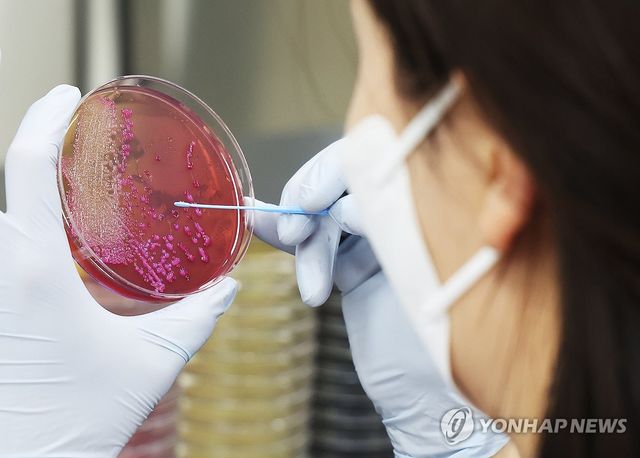
식중독 검사

(홍성=연합뉴스) 이주형 기자 = 충남의 한 축제장에서 제공된 음식을 먹은 지역민들이 집단으로 식중독 의심 증세를 보여 보건 당국이 조사에 나섰다.
17일 충남소방본부, 홍성군 등에 따르면 전날 열린 '2025년 제1회 충남연합회장기 노인건강대축제' 행사장에서 점심으로 제공된 떡과 도시락을 먹은 노인 103명이 복통과 구토를 비롯한 식중독 의심 증세를 보인다는 신고가 접수됐다.
이 중 74명이 병원으로 이송됐다. 17일 현재 55명이 퇴원하고 19명은 입원 중이다.
29명은 비교적 가벼운 증세라서 행사장에서 바로 귀가했다.
행사는 대한노인회 충남연합회가 도내 노인복지와 건강 함양을 위해 마련한 것으로 전체 참석자 850명 대부분이 고령층인 것으로 알려졌다.
이들이 점심을 먹었던 16일 정오 무렵 홍성의 기온은 20.3도로 비교적 포근했다.
홍성보건소 등은 보존식 등 환경 검체와 인체 검체를 확보해 역학조사를 벌이고 있다.
coolee@yna.co.kr
Copyright ⓒ 연합뉴스 무단 전재 및 재배포 금지
본 콘텐츠는 뉴스픽 파트너스에서 공유된 콘텐츠입니다.